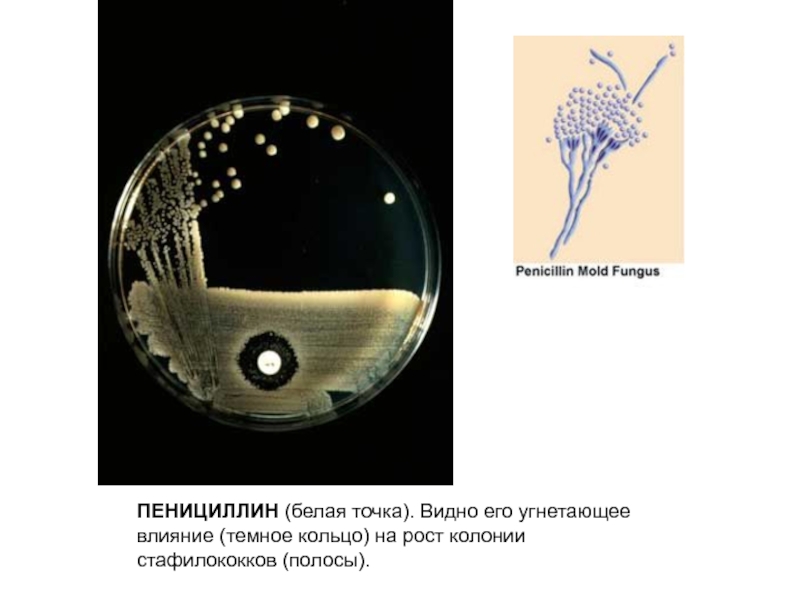

)
Суспензия, таблетки, капли для приема внутрь, раствор для инъекций.
Антибиотик пенициллин ингибиторзащищенный.
Аугментин GlaxoSmithKline
(amoxicillin + clavulanic acid | амоксициллин + клавуланат )
Раствор внутривенный (порошок для приготовления).
Антибиотик пенициллин ингибиторзащищенный.
Аугментин GlaxoSmithKline
(amoxicillin + clavulanic acid | амоксициллин + клавуланат )
Таблетки, порошок для приготовления суспензии.
Антибиотик пенициллин ингибиторзащищенный.
Курам Biochemie
(amoxicillin + clavulanic acid | амоксициллин + клавуланат )
Таблетки, порошок для приготовления раствора.
Антибиотик пенициллин ингибиторзащищенный.
Панклав Hemofarm
(amoxicillin + clavulanic acid | амоксициллин + клавуланат )
Таблетки .
Антибиотик пенициллин ингибиторзащищенный.
Ранклав Ranbaxy
(amoxicillin + clavulanic acid | амоксициллин + клавуланат )
Таблетки .
Антибиотик пенициллин ингибиторзащищенный.
Ампициллин + оксациллин Акрихин
(ampicillin + oxacillin | ампициллин + оксациллин )
Капсулы.
Антибиотик пенициллин комбинированный.
Оксациллина натриевая соль
(oxacillin | оксациллин )
Таблетки .
Антибиотик, пенициллин полусинтетический.
Ретарпен Biochemie
(benzathine benzylpenicillin | бензатинбензилпенициллин )
Раствор для инъекций.
Антибиотик, пенициллин природный.
Экстенциллин Rhone-Poulenc Rorer
(benzathine benzylpenicillin | бензилпенициллина бензатин )
Раствор для инъекций.
Антибиотик, пенициллин природный.
Пенициллин G - натриевая соль Биохеми | Biochemie
(benzylpenicillin | бензилпенициллин )
Раствор для инъекций.
Антибиотик, пенициллин природный.
Прокаин Пенициллин G Biochemie
(benzylpenicillin | прокаин пенициллин )
Раствор для инъекций. Антибиотик, пенициллин природный.
Клиацил | Hoechst Marion Roussel
(phenoxymethylpenicillin | феноксиметилпенициллин )
Таблетки, порошок для приготовления раствора.
Антибиотик, пенициллин природный.
Оспен | Biochemie
(phenoxymethylpenicillin | феноксиметилпенициллин )
Таблетки, капсулы, гранулы для приготовления раствора, сироп.
Антибиотик, пенициллин природный.
Амоксициллин | (amoxicilin | амоксициллин )
Таблетки .
Антибиотик, пенициллин, аминопенициллин.
Амоксициллин | Hemofarm(amoxicilin | амоксициллин )
Капсулы, суспензия.
Антибиотик, пенициллин, аминопенициллин.
Амоксициллин | Schreya Life Sciences
(amoxicillin | амоксициллин ) Капсулы.
Антибиотик, пенициллин, аминопенициллин.
Оспамокс | Biochemie
(amoxicillin | амоксициллин )
Таблетки, капсулы, гранулы для приготовления раствора.
Антибиотик, пенициллин, аминопенициллин.
Флемоксин Солютаб | Astellas
(amoxicillin | амоксициллин ) Таблетки растворимые .
Антибиотик, пенициллин, аминопенициллин.
Ампициллин | Hemofarm
(ampicillin | ампициллин ) Капсулы, суспензия.
Антибиотик, пенициллин, аминопенициллин.
Ампициллина тригидрат | Акрихин
(ampicillin | ампициллин )
Таблетки .
Антибиотик, пенициллин, аминопенициллин.
Ампициллина тригидрат | Органика
(ampicillin | ампициллина тригидрат )
Таблетки .
Антибиотик, пенициллин, аминопенициллин.
Упсампи | Bristol-Myers Squibb
(ampicillin | ампициллин )
Капсулы.
Антибиотик, пенициллин, аминопенициллин.